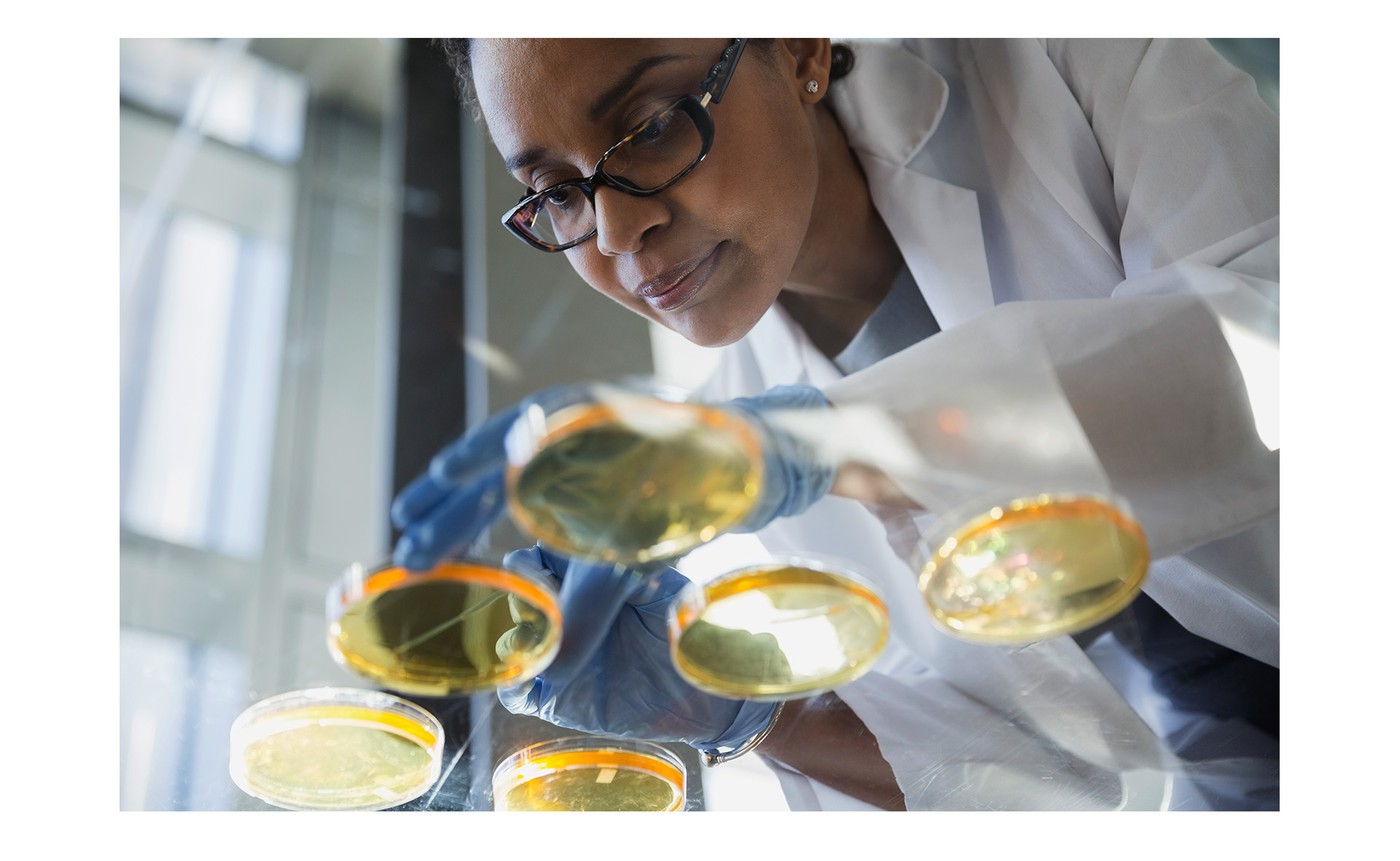

Participer à l’effort de recherche
Dynamiser la communication institutionnelle d'une fondation de recherche médicale
LES ATTENTES
- REFONDRE LE SITE INSTITUTIONNELE AFIN DE RAFRAICHIR L'IMAGE DE LA FONDATION
- POUVOIR EFFECTUER DES CAMPAGNES DE COLLECTE EN LIGNE
- DISPOSER D'UN OUTIL DE GESTION SIMPLE ET ÉVOLUTIF
Créée en 2005, Toulouse Cancer Santé est une fondation de recherche médicale contre le cancer, au service de l’Oncopole de Toulouse. La fondation attendait de nous que nous puissions l’accompagner dans sa démarche de communication en ligne et dans sa volonté d’élargir ses campagnes de collecte auprès d’un public plus large.
NOTRE APPROCHE
- DÉFINITION DES NOUVEAUX CODES GRAPHIQUES
- DÉVELOPPEMENT D'UN OUTIL DE COLLECTE EN LIGNE SUR MESURE
- PRISE EN COMPTE DES CONSULTATIONS ET DES DONS SUR MOBILE
La refonte du site internet a permis à la fondation d’actualiser sa communication et de diffuser plus largement sur ses valeurs et ses objectifs sur des cibles plus jeunes. La gestion responsive de ce site permet de s’adresser et de collecter des dons sur des cibles en mobilité. Nous pensons que notre souplesse et notre réactivité nous ont permis de rester ambitieux malgrè le contexte politique dans lequel nous avons dû le faire évoluer.

Durée du projet
Compétences
- Gestion de projet
- Direction artistique
- Intégration responsive
- Développement php
Outils
- Wordpress
Partenaires
Gestion globale du projet